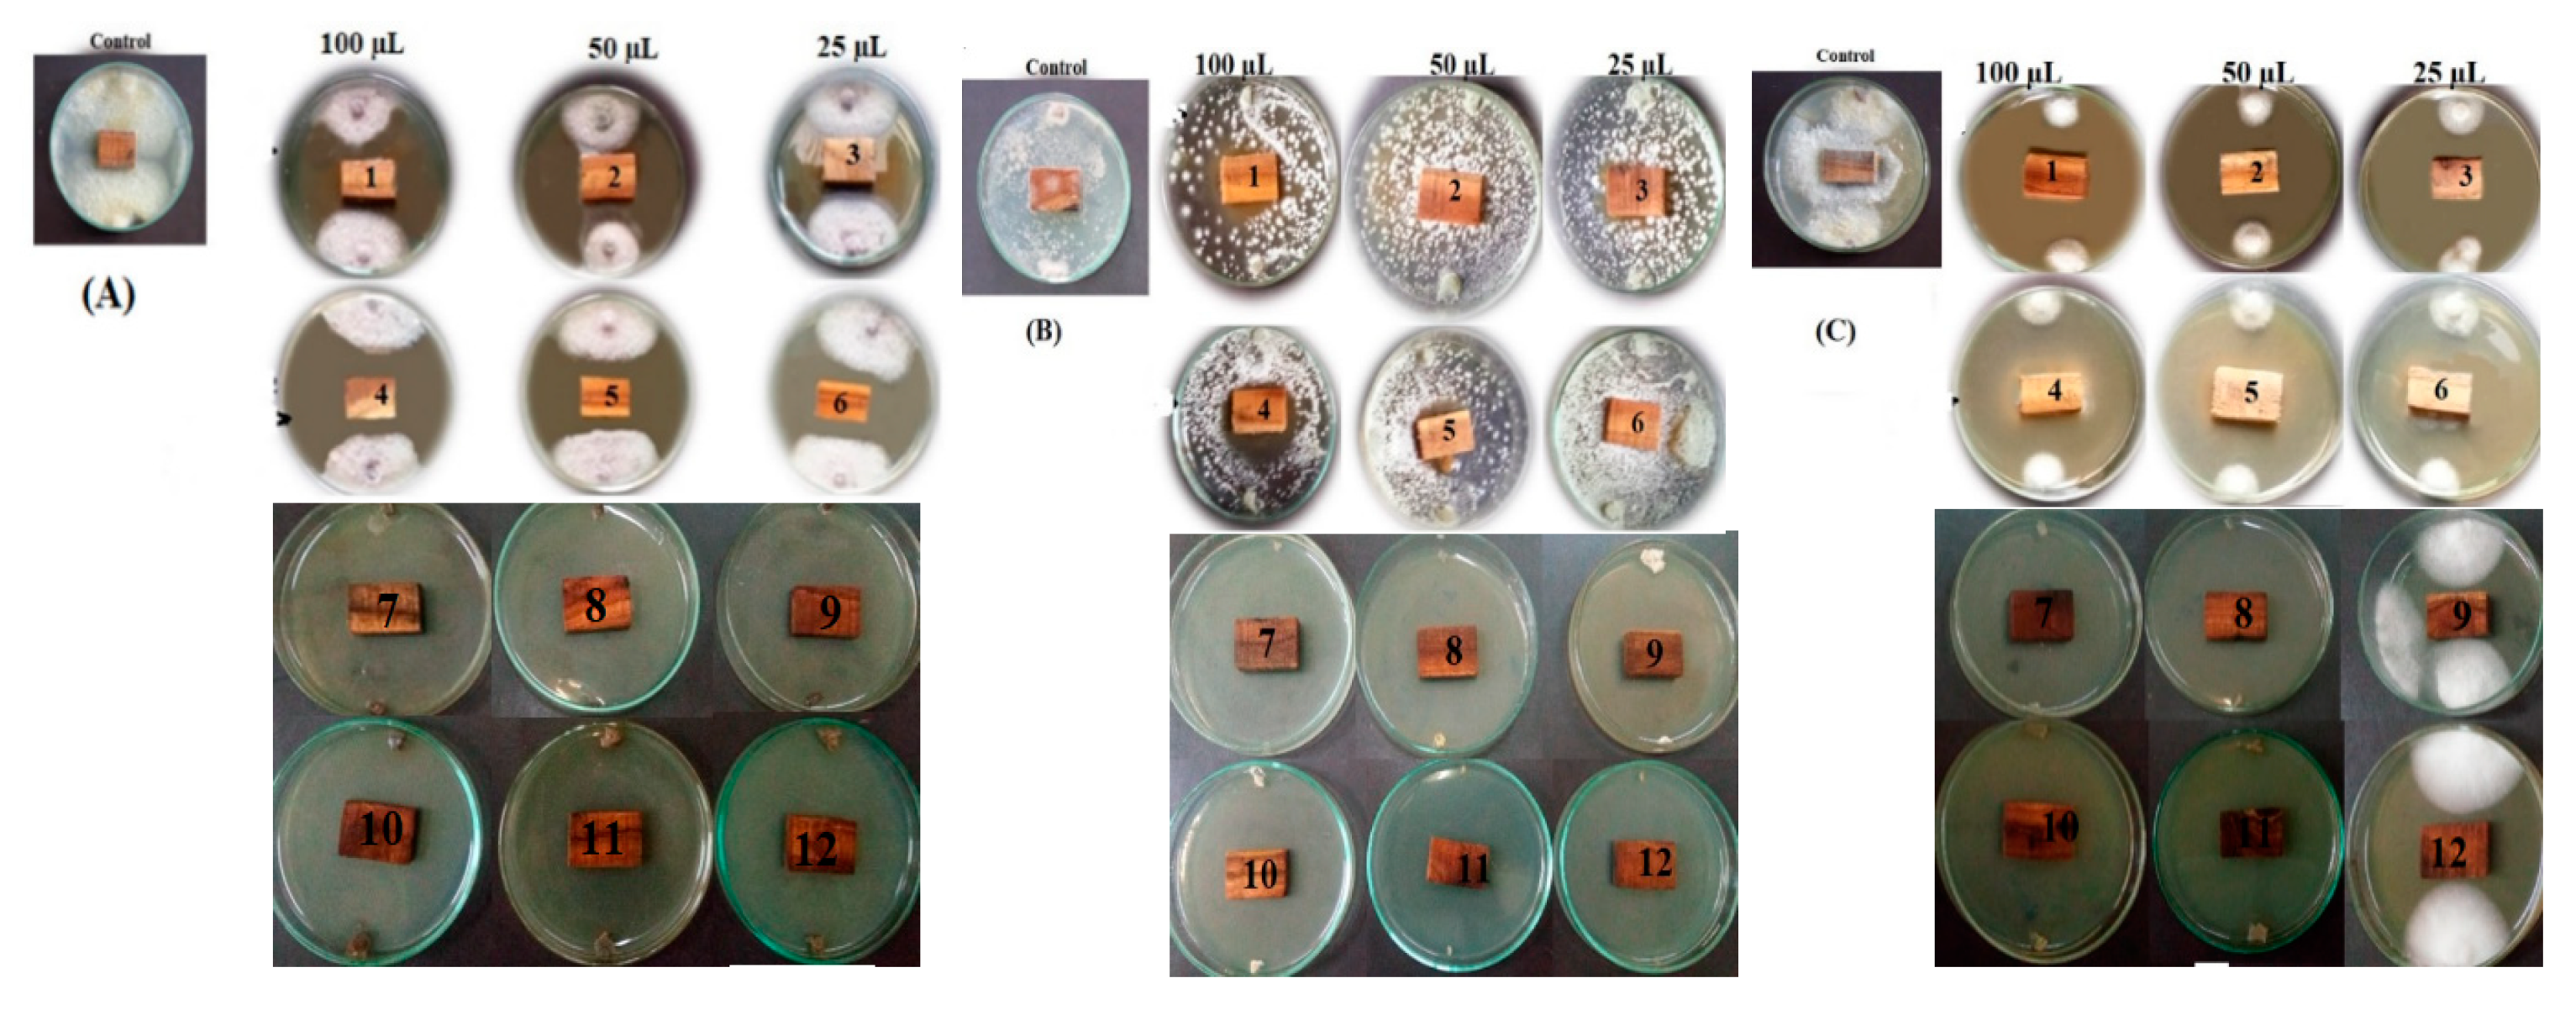
Processes 08 00275 g006

Abstract
The present study described the possibility of using wood-treated oil-fungicide of lemon-scented gum (Corymbia citriodora) from newly emerged leaves and unripened fruits against the infestation of Fusarium culmorum, Rhizoctonia solani and Penicillium chrysogenum. Air-dried wood samples of Melia azedarach were treated with the extracted oils from leaves and unripened fruits from C. citriodora. The main chemical constituents identified in the essential oil (EO) from leaves were citronellal (55.31%), citronellol (21.03%) and isopulegol (10.79%), while in unripened fruits were α-pinene (17.86%), eudesmol (13.9%), limonene (9.19%), γ-terpinen (8.21%), and guaiol (7.88%). For recovered oils (ROs), the major components from leaves were D-limonene (70.23%), γ-terpinene (13.58%), β-pinene (2.40%) and isopregol (2.23%), while, 4-terpineol (21.35%), cis-β-terpineol, (19.33%), D-limonene (14.75%), and γ-terpinene (7.42%) represented the main components in fruits. EOs from leaves and fruits at the amounts of 100, 50 and 25 µL showed the highest inhibition percentage (IP) of 100% against F. culmorum and P. chrysogenum compared to control treatment, while at the amounts of 100, and 50 µL showed 100% IP of R. solani. Wood treated with ROs from leaves and fruits showed IPs of 96.66% and 93.33%, respectively, against the growth of R. solani. The mass spectra of the main components of C. citriodora leaves and fruits’ EOs have been recorded in electron ionization mode at 70 eV and fragmentation has been reported and discussed. On the other hand, different quantum parameters such as the heat of formation, ionization energy total energy, binding energy, electronic energy and dipole moment using the modified neglect of diatomic overlap (MNDO) semi-empirical method have been calculated.
1. Introduction
Essential, fixed and recovered oils as well as the other natural extracts (phenolic, flavonoids, saponins, alkaloids and tannins) from medicinal plants have great effects as antifungal agents against the growth of molds that grow on lignocellulosic materials such as wood, linen, ancient manuscripts, pulp and paper, archaeological artifacts and wood products [1,2,3,4,5,6,7,8,9].
A number of studies have demonstrated the antimicrobial properties of Eucalyptus essential oils (EOs) and their antimicrobial effects against a wide range of microorganisms have been studied. These species showed potential antifungal and antibacterial activities, especially E. citriodora (lemon-scented gum) EO, which has been shown to have a wide spectrum of antifungal activity [10,11,12,13,14].
Corymbia citriodora (C. citriodora) (Hook.) K.D. Hill and L.A.S. Johnson (Eucalyptus citriodora (Hook.) has been reported to be a good source oil (lemon-scented Eucalyptus), which is used for pharmaceutical, perfumery and other related industries and was reported as non-toxic under the GRAS (Generally Regarded as Safe) category by Food and Drug Administration of the USA [15]. C. citriodora leaf EOs have a broad spectrum of uses such as antibacterial [16,17], pesticide [18,19,20], nematicidal [21], antifungal [13,17], and herbicidal [22] uses, and moderate to strong antioxidant activities [23] being rich in monoterpenoids compounds [23,24,25].
There are several bioactive compounds such as α-citronellal, citronellol acetate, α-citronellol, isopulegol, eucalyptol that are the main compounds that have been identified in the EOs extracted from C. citriodora; from the tree grown in Egypt from air-dried leaves [17]; while cis-geraniol, 3-hexen-1-ol, citronellol acetate, 5-hepten-1-ol, 2,6-dimethyl, and citronellal were the major components in the green leaf EO of C. citriodora [26]. Citronellal, β-citronellol, and isopulegol were the major monoterpenoids in the leaf EO of the tree planted in India [23,27]. Volatile composition of the leaves of E. citriodora grown in the Delhi region showed the presence of reported α-pinene, β-pinene, sabinene and α-thujene as the major compounds [28].
Several studies have reported the antifungal and antibacterial activities of the EOs from C. citriodora [10,12,14,17,29,30]. For example, strong antifungal activity against Macrophomina phaseolina, Colletotrichum lindemuthianum, Fusarium oxysporum f. sp. lycopersici, Helminthosporium oryzae, Alternaria triticina, Rhizoctonia solani, and Alternaria solani was found with the application of C. citriodora oil compared with Mancozeb [13]. Filter paper disks impregnated with C. citriodora leaf EO at 10 µL showed good activity against E. coli and S. aureus Elaissi [30]. With the presence of sabinene and terpinen-4-ol as main compounds in the essential oil of C. citriodora, the EO displayed potent antifungal activity against Trichophyton rubrum [31].
Recovery oil (RO) using n-hexane solvent from the distillate of Matricaria chamomilla fresh flowers after obtaining the EOs were reported to have potential antifungal activity against A. niger and A. terreus [6]. Therefore, the present study firstly aimed to extract the essential and recovery oils from C. citriodora leaves and unripened fruits; and secondly to explore their bioactivity as wood-biofungicides; and, finally, modified neglect of diatomic overlap (MNDO) quantum chemical studies have been reported.
2. Materials and Methods
2.1. Oil Extraction
C. citriodora plant materials (leaves and unripened fruits) were cut into small pieces then 100 g from each plant were hydrodistilled using the Clevenger apparatus for 3 h [32]. After collecting the essential oils, the recovered oils dissolved in water from the hydrodistillation were isolated using n-hexane solvent. The n-hexane fraction or layer was separated using a funnel separator [6]. The essential and n-hexane oils were stored in glass tubes in the refrigerator at 4 °C until chemical and antifungal analyses.
2.2. Gas Chromatography–Mass Spectrometry (GC–MS) Analysis of the Oils
Essential oils and n-hexane recovered oils were analyzed for their chemical composition using Focus GC-DSQ (Gas Chromatography-Dual Stage Quadrupole) Mass Spectrometer (Thermo Scientific, Austin, TX, USA) with a direct capillary column TG–5MS (30 m x 0.25 mm x 0.25 µm film thickness, Agilent, Palo Alto, CA, USA) apparatus at Atomic and Molecular Physics Unit, Experimental Nuclear Physics Department, Nuclear Research Centre, Egyptian Atomic Energy Authority, Inshas, Cairo, Egypt. The column oven temperatures, injection properties, compound separation and identification can be found in previous works [3,6,33].
2.3. Antifungal Activity of Wood Treated with Oils
Three common molds namely Fusarium culmorum, Rhizoctonia solani and Penicillium chrysogenum with their accession numbers of MH352452, MH352450, and MH352451, respectively, were used for the bioassay [3,7,9]. Oils were applied at the amounts of 0, 25, 50, and 100 µL. Air-dried wood samples of Melia azedarach were prepared with the approximate dimension of 0.5 × 1 × 2 cm then autoclaved at 121 °C for 20 min and left to cool. Nine wood samples were treated with each concentration (three for each fungus) from each oil. Wood samples without oil treatments were used as a control. The antifungal effect of treated wood was measured following our previous works with minor modification [3,34,35,36,37]
2.4. Statistical Analysis
Data of the antifungal activity were statistically analyzed with three factors (plant part, type of oil and the concentration) using analysis of variance, Statistical Analysis Software (SAS) system [38]. The differences among the mean of treatments were recorded using Fisher’s Least Significant Difference LSD0.05.
3. Results
3.1. Chemical Composition and Mass Spectrometric Investigations
3.1.1. Chemical Composition of Corymbia Citriodora Leaves and Fruits’ Essential Oils
The identified chemical composition of C. citriodora leaf EO is shown in Table 1 and represented 14 compounds. The main chemical components in C. citriodora leaf EO were citronellal (55.31%), citronellol (21.03%), isopulegol (10.79%), citronellol acetate (2.31%), citronellic acid (2.08%), and caryophyllene (1.32%). The identified chemical composition of unripe fruits’ EO comprised 27 compounds (Table 2). The main chemical components in C. citriodora unripe fruits EO were α-pinene (17.86%), eudesmol (13.9%), limonene (9.19%), γ-terpinen (8.21%), and guaiol (7.88%).
Table 1.
Phytochemicals screening of Corymbia citriodora leaf essential oil by gas chromatography–mass spectrometry (GC–MS).
Table 2.
Phytochemicals screening of Corymbia citriodora fruit essential oil by GC–MS.
3.1.2. Mass Spectrometric Investigations of the Main Components of Corymbia Citriodora Leaves and Fruits’ Essential Iils
The 70 eV mass spectra of the major constituents of C. citriodora leaf EO are recorded and discussed as shown in Figure 1. The mass spectrum (MS) of the peak at retention time (RT) 13.63 min (Figure 1a) represent the citronellal component suggesting its molecular formula C10H18O (Table 1). The molecular ion peak (MIP) was observed at m/z 154 with relative intensity (RI) = 5% and the peak at 69 (RI = 100%) representing the base peak (BP). Fragment ion (FI) of m/z 136 (10%), 95 (60%), 84 (20%) and 55 (60%) were also reported.

Figure 1.
The 70 eV mass spectrum of (a) citronellal, (b) citronellol, and (c) isopulegol in C. citriodora leaves’ essential oil. M stands for mass and Z stands for charge number of ions.
The MS of the peak at RT 20.39 min (Figure 1b) represent citronellol component suggesting its molecular formula C10H20O (Table 1). The MIP was observed at m/z 156 with RI = 3% and the peak at 69 (RI = 100%) representing the BP. Other significant FI observed were m/z 138 (12%), 123 (15%), 95 (43%), 81 (65%), 67 (95%) and 55 (62%).
The MS of the peak at RT 15.77 min (Figure 1c) represent isopulegol component suggesting its molecular formula C10H18O (Table 1). The MIP was observed at m/z 154 with RI = 5% and the peak at 67 (RI = 100%) representing the BP. Significant FI with m/z 121 (56%), 95 (57%), 84 (60%) and 55 (72%) were also observed.
From the fragmentation pattern of citronellol (citronellal isomer) compound, it is shown that the first fragmentation pathway of the molecular ion (MI) of citronellol is the formation of the FI at m/z 138 (Figure 2). This could be could be explained by the formation of the [M-H2O]+• ion, which loses the H2O from the MI. In addition, the ion [M-H2O]+• can be fragmented in three ways: first by loss of a CH3• radical to produce the fragment ion [M-H2O-CH3]+ at m/z 123. The second way is by the loss of a C3H7• radical to produce [M-H2O-C3H7]+ at m/z 95. The third way is by the loss of C4H9• to produce [M-H2O-C4H9]+ at m/z 81 [39]. The second fragmentation pathway of the MI of citronellol is by the simple cleavage to produce directly the FI C5H9+ with m/z 69, which represents the BP in the MS as shown in Figure 1a.
Figure 2.
Fragmentation pattern of citronellol under electron ionization 70 eV.
The 70 eV mass spectra of the major constituents of C. citriodora fruits’ EO are recorded and discussed as shown in Figure 3 and the chemical composition are shown in Table 2.

Figure 3.
The 70 eV mass spectrum of (a) α-pinene (b) eudesmol (c) limonene, (d) γ-terpinene and (e) guaiol in C. citriodora unripe fruits’ essential oil. M stands for mass and Z stands for charge number of ions.
The MS of the peak at RT 3.47 min (Figure 3a) represent α-pinene component suggesting its molecular formula is C10H16 (Table 2). The MIP was observed at m/z 136 with RI = 10% and the peak at 93 (RI = 100%) represent the BP. Fragment with m/z 77 (40%) was observed as other significant on.
The MS of eudesmol has been recorded and investigated as shown as in Figure 3b suggesting its molecular formula is C15H26O. The MIP was observed at m/z 222 with RI = 3% and the peak at 161 (RI = 100%) representing the BP. Other significant FIs observed were m/z 189 (65%), 133 (68%), 107 (62%), 91 (65%) and 59 (83%). Limonene MS has been recorded as shown in Figure 3c suggesting its molecular formula C10H16. The MIP was observed at m/z 136 with RI = 15% and the peak at m/z 68 (RI = 100%) represent the BP. Other significant FIs observed were m/z 121 (20%) and 93 (70%). γ-Terpinene MS was as shown in Figure 3d suggesting its molecular formula is C10H16. The MIP was observed at m/z 136 with RI = 25% and the peak at m/z 93 (RI = 100%) representing the BP. Other significant FIs observed were m/z 121(21%) and 77(40%). Guaiol MS presented in Figure 3c suggesting its molecular formula is C15H26O. The MIP was observed at m/z 222 with RI = 3% and the peak at m/z 161 (RI = 100%) representing the BP. Other significant FIs observed were m/z 189(20%), 119 (40%), 105 (82%), 81 (60%) and 59 (85%).
3.1.3. Chemical Composition of Corymbia Citriodora Leaves and Fruits’ Recovery Oils
The major components of the C. citriodora leaf recovery oils (RO, Table 3) were D-limonene (70.23%), γ-terpinene (13.58%), β-pinene (2.40%) and isopregol (2.23%), while, α-terpineol (21.35%), cis-β-terpineol (19.33%), D-limonene (14.75%), γ-terpinene (7.42%) and (1α,2β,5α)-bicyclo[3.1.0]hexan-2-ol, 2-methyl-5-(1-methylethyl) (6.30%) represented the main components of C. citriodora fruit RO (Table 4).
Table 3.
Phytochemicals screening of Corymbia citriodora leaf recovered oil by GC–MS.
Table 4.
Phytochemicals screening of Corymbia citriodora fruits’ recovered oil by GC–MS.
The MS of D-limonene component of C. citriodora leaf RO at 70 eV (Figure 4a) shows that the MIP at m/z 136 have RI = 40% (stable molecular ion) and the other FIs at m/z 121(30%), 93(90%) and 68(100%) represent the BP in D-limonene MS.

Figure 4.
The 70 eV mass spectrum of D-limonene (a), γ-terpinene (b), β-pinene (c), and isopregol (d) components of Corymbia citriodora leaves’ recovery oil.
The MS of γ-terpinene component of C. citriodora leaf RO at 70 eV are recoded as shown in (Figure 4b). Using MS one can note that the MIP at m/z 136 have RI = 40% and the other FIs are 121 (32%) and 77 (30%). The fragmentation processes of γ-terpinene achieved by mean of their unimolecular dissociation of the parent ion by loss of C3H7 radical to produce the main fragment ion (BP) [M-C3H7]+ at m/z = 93
The MS of β-pinene component of C. citriodora leaf RO at 70 eV (Figure 4c) shows that the MIP at m/z 136 have RI = 18% the most intense peak (InP) at m/z 93 with RI = 100%, which represent the FI [M-C3H7]+ due to the loss of C3H7 radical from the parent ion, and the other FIs are 79 (25%) and 69 (30%).
The MS of isopregol component of C. citriodora leaf RO 70 eV (Figure 4d) shows that the MIP at m/z 154 have RI = 20% and the other FIs 121 (60%), 79 (45%) and 68 (85%), while the FI at m/z 93 represent the BP with RI = 100%.
The MS of α-terpineol component of C. citriodora fruits RO at 70 eV (Figure 5a) show that the MIP at m/z 154 have RI = 15%, the most InP at m/z 71 with RI = 100%, and the other FIs are 111 (50%) representing the FI [M-C3H7]+, 93 (58%), 71 (100%) and 55 (25%).

Figure 5.
The 70 eV mass spectrum of 4-Terpineol (a), cis-β-Terpineol (b), γ-Terpinen (c), and (1α,2β,5α)-Bicyclo[3.1.0]hexan-2-ol,2-methyl-5-(1-methylethyl) (d) components of Corymbia citriodora fruits’ recovery oil.
The MS of cis-β-terpineol component of C. citriodora fruits RO at 70 eV (Figure 5b) shows that the MIP at m/z 154 have RI = 3%, the most InP at m/z 71 with RI = 100%, and the other FIs are 121 (35%), 93 (55%) and 81 (65%).
The MS of γ-terpinene component of C. citriodora fruits RO at 70 eV (Figure 5c) show that the MIP at m/z 136 have RI = 30% (stable molecular ion peak), the most InP at m/z 93 with RI = 100% representing [M-C3H7]+ ion, and the other FIs are 121 (25%) and 77(45%).
The MS of 2-methyl-5-(1-methylethyl)-(1α,2β,5α)-bicyclo[3.1.0]hexan-2-ol component of C. citriodora fruits RO at 70 eV (Figure 5d) show that the MIP at m/z 154 have RI = 10%, the most InP at m/z 71 with RI = 100%, and the other FIs are 121 (65%), 93 (92%) and 55(45%).
3.2. Computation Method
The geometry of the studied molecules has been optimized based on semi-empirical calculations, using the molecular modeling program Hyperchem7.5 (W.Thiel 2003, HyperChemTM, Release 7.5 Pro 2002). Semi-empirical calculations were carried out using the routine MNDO and Polak–Ribiere conjugated gradient algorithm. For the optimized structure of the neutral and cation states, geometry optimization mode was carried out to give the molecular properties including heat of formations, total energy, binding energy, electronic energy and nuclear energy and dipole moment [40]. From the calculated data of the studied compounds (Table 5), values were obtained for heat of formation, ionization, total, binding, electronic energies and dipole moment. These thermochemical data are necessary in the description of the conformational properties of the studied molecules [41].
Table 5.
Thermodynamic data of the studied molecules calculated within the modified neglect of diatomic overlap (MNDO) framework.
From the calculated data of the studied molecule (Table 5), one can observe that the negative values of the heat of formations ∆F(M) and total energy for group 1 (citronellol, isopulegol, eudesmol guaiol, and isopregol) neutral molecules have negative values that mean these molecules are stable and the citronellol molecule is the most stable. This is due to the presence of the OH group in their structures, while group 2 α-pinene, limonene and γ-terpinene have the positive values of heat of formations. From these values the second group is relatively less stable than the first group which has OH group in their structures. This is confirmed by the values of dipole moment, hence the first group has approximately the same dipole moment(1.401, 1.374, 1.353, 1.447 and 1.227) in comparison with the second group (0.113, 0.122 and 0.028).
3.3. In Vitro Visual Observations of Dual Fungal Growth Against Oil-Treated Wood
To test the antifungal properties of essential (EO) and recovered (RO) oils from leaves and fruits of C. citriodora, oil-treated wood were bio-assayed against the growth of three fungi (F. culmorum, R. solani and P. chrysogenum) compared to control treatments in Figure 6. Nearly no growth of F. culmorum, R. solani and P. chrysogenum were found over wood treated with C. citriodora leaves and fruits oils after 14 days from incubation. On the other hand, the treated wood with EOs showed complete inhibition to the growth of F. culmorum and P. chrysogenum at all the oil amounts used (100, 50 and 25 µL), and also, at the amount of 100 and 50 µL of both oils, no growth of R. solani was observed. By visual observation and compared to control treatment, nearly no inhibition was found around the treated wood with ROs against the growth of P. chrysogenum but, also, no growth was observed over the treated wood samples. The extract from the unripened fruit prevents surrounding fungal growth in comparison to the extract from the leaf. Also, when little growth was observed it differed in appearance but it was still stopped by the ROs.
Figure 6.
In vitro antifungal bioassay of treated-wood with (1,2,3) C. citriodora leaf recovered oil; (4,5,6) C. citriodora fruit recovered oil; (7,8,9) C. citriodora leaf essential oil and (10,11,12) C. citriodora fruit essential oil. (A) Fusarium culmorum, (B) Penicillium chrysogenum, (C) Rhizoctonia solani.
3.4. Antifungal Activity of the Oils
Overall, leaves and fruits of C. citriodora showed the highest activity against F. culmorum and P. chrysogenum (Figure 7a). EOs were observed much higher activity against the studied fungi than ROs (Figure 7b). In addition, with increasing the oil amount, the activity was increased compared to the control (Figure 7c). The antifungal activity values of treated wood with C. citriodora leaf and fruits’ EOs at the amounts of 100, 50 and 25 µL in Table 6 show that the highest inhibition percentage (IP) of 100% was observed against F. culmorum and P. chrysogenum compared to the control treatment. The treated wood with both EOs at the amounts of 100, and 50 µL showed 100% IP of R. solani.

Figure 7.
Overall bioactivity of C. citriodora (a) part source, (b) oil source and (c) oil amount against fungal linear growth of F. culmorum, P. chrysogenum and R. solani.
Table 6.
Inhibition percentages of fungal growth (%) as affected by wood treated with C. citriodora oils with different amounts.
The treated wood with ROs from leaves and fruits observed less activity against the growth of F. culmorum and P. chrysogenum, where IP reached 46.66% against F. culmorum on wood treated with C. citriodora leaf RO in the amount of 100 µL. Also, IP showed 60% against P. chrysogenum with wood treated at 100 µL of C. citriodora fruit RO. The ROs from leaves and fruits showed IPs of 96.66% and 93.33% against the growth of R. solani in the oil amount of 100 µL.
4. Discussion
In the present study, gas chromatography–mass spectrometry (GC–MS) with some calculations that were reported in the computation method was used for identification of the phytocompounds in EO and RO from C. citriodora leaves and unripe fruits [43,44,45]. For example, the fragmentation pathway of some identified main compounds such as D-limonene has been reported and discussed by Abd El-kareem et al. [42].
The main chemical constituents in EO from C. citriodora leaves were citronellal, citronellol and isopulegol, while in the fruits were α-pinene, eudesmol, limonene, γ-terpinene, and guaiol. The main compounds found in the recovery oils from leaves were D-limonene, γ-terpinene, β-pinene and isopregol, while, α-terpineol, cis-β-terpineol, D-limonene, γ-terpinene and (1α,2β,5α)-bicyclo[3.1.0]hexan-2-ol, 2-methyl-5-(1-methylethyl) were found in fruits. These compounds have been identified in the oils from Eucalyptus species, especially C. citriodora, with significant antimicrobial and antioxidant activities.
Our previous work showed that the leaf EO from C. citriodora leaves had a potential antimicrobial activity against Listeria monocytogenes, Bacillus cereus, Micrococcus flavus, Staphylococcus aureus, Dickeya solani, Escherichia coli, Pectobacterium atrosepticum, Pectobacterium carotovorum subsp. carotovorum, Pseudomonas aeruginosa, Aspergillus flavus, A. ochraceus, A. niger, Candida albicans, Penicillium funiculosum and P. ochrochloron with the presence of α-citronellal, α-citronellol, citronellol acetate, isopulegol, eucalyptol, and citronellic acid as the main compounds [17].
Other studies reported that the main compounds of the EOs of C. citriodora leaves were α-citronellal and isopulegol [46]; citronellal, β-citronellol, and isopulegol [23]; citronellal and β-citronellol [28]; β-citronellal in plants grown in Brazil [47]. Citronellal, citronellol, Neo-isopulegol, E-caryophyllene, iso-isopulegol, and citronellyl acetate were found as the main compounds in the EO of C. citriodora from Benin [48]; α-citronellal, citronellol acetate, α-citronellol, and isopulegol were also the main compounds [20]; α-pinene and 1.8-cineole the main compounds in the plant grown in Tunisia [30]. α-pinene and α-terpineol have been shown antimicrobial activity [49], which are found in C. citriodora leaf oil. Limonene and other monoterpenes (linalool, linalyl acetate, bergapten, citropten, bergamottin, γ-terpinen, α-pinene and β-pinene) have good biological properties [17,50]. The major components of EO in E. citriodora from the zoological garden in Giza, Egypt, were 5-hepten-1-ol, 2,6-dimethyl, 3-hexen-1-ol, cis-geraniol, citronellol acetate, and citronellal [26]. Limonene, E-nerolidol, and E-farnesol which exhibited high antifungal activity [51,52].
E. citriodora EO also inhibits the growth of phyto- and post-harvest pathogens [12,13,53], and its antifungal activity is attributed to citronellal, the major volatile constituent of this EO [12]. Significant inhibition of growth of Rhizoctonia solani was observed in Citronella (83.53%), and Lemon-tulsi (70.39%), Eucalyptus (68.63%), Pepper Mint (55.69%), and Patchauli (52.75%) which also effectively reduced the growth of the fungus [54]. E. citriodora and its major constituent citronellal was effective against rice pathogen R. solani and fully inhibited growth by the minimum concentrations [55]. Also, the synergism that occurred between citronellal and linalool showed strong antifungal activity [56]. Recently, the EO from C. citriodora leaves which contain α-citronellal (56.55%), α-citronellol (14.89%), and citronellol acetate (13.04%) was found to be highly toxic to the bacterial pathogen Ralstonia solanacearum phylotype II, the causal agent of brown rot disease [57]. The recovered compounds from hydrodistillation selected Lamiaceae species showed good antiradical and antioxidant activity [58]. Water-soluble oil was recovered by hexane extraction with 82.7%–83.3% dissolved in hot water and 90.0%–90.5% dissolved cold water from Tagetes minuta [59]. Recently, oil was recovered from hydrosol of Matricaria chamomilla flowers and showed good antifungal activity against A. niger [6]. Other study showed that linalyl acetate and limonene were recovered from from bergamot juice by supercritical and liquid CO2 [60].
5. Conclusions
In the present study, the treated Melia azedarach wood with C. citriodora leaf and fruits essential oils (25, 50 and 100 µL) showed the highest antifungal activity (100% inhibition) against F. culmorum and P. chrysogenum. Treated wood with both essential oils at 50 and 100 µL observed potent activity against the growth of R. solani with an inhibition percentage 100%. Recovered oils from leaves and fruits showed good activity against R. solani, where the inhibition percentage reached 96.66%, and 93.33%, respectively. Additionally, weak to moderate activity was observed against F. culmorum and P. chrysogenum as wood treated with recovered oils from leaves and fruits. Therefore, both oils could be used as natural antifungal agents for the treatment of several plant infection diseases and as wood bio-fungicide that can be used for packaging fruits or vegetables. Also, the mass spectra of the major components are recoded and discussed, where the main fragment ions were observed at m/z 67, 68, 69, 71, 93 and 161 for the main components of the studied samples. From MNDO calculations, citronellol molecule has the most negative values of heat of formations and it is the most stable molecule, while α -pinene is the least stable molecule.
Author Contributions
S.I.B., R.A.N., M.S.M.A.E.-K., H.M.A. and M.Z.M.S. designed the experiments, conducted the laboratory analyses, wrote parts of the manuscript, and interpreted the results; all coauthors contributed to writing and revising the article. All authors have read and agreed to the published version of the manuscript.
Funding
This research was funded by Researchers Supporting Project number (RSP-2019/123) King Saud University, Riyadh, Saudi Arabia.
Conflicts of Interest
The authors declare no conflicts of interest.
References
- Mansour, M.M.A.; EL-Hefny, M.; Salem, M.Z.M.; Ali, H.M. The Biofungicide activity of some plant essential oils for the cleaner production of model linen fibers similar to those used in ancient egyptian mummification. Processes 2020, 8, 79. [Google Scholar] [CrossRef]
- Salem, M.Z.M.; Hamed, S.A.M.; Mansour, M.M.A. Assessment of efficacy and effectiveness of some extracted bio-chemicals as bio-fungicides on Wood. Drvna Ind. 2019, 70, 337–350. [Google Scholar] [CrossRef]
- Salem, M.Z.M.; Behiry, S.I.; EL-Hefny, M. Inhibition of Fusarium culmorum, Penicillium chrysogenum and Rhizoctonia solani by n-hexane extracts of three plant species as a wood-treated oil fungicide. J. Appl. Microbiol. 2019, 126, 1683–1699. [Google Scholar] [CrossRef] [PubMed]
- Salem, M.Z.M.; Mansour, M.M.A.; Elansary, H.O. Evaluation of the effect of inner and outer bark extracts of Sugar Maple (Acer saccharum var. saccharum) in combination with citric acid against the growth of three common molds. J. Wood Chem. Technol. 2019, 39, 136–147. [Google Scholar] [CrossRef]
- Mohamed, W.A.; Mansour, M.M.A.; Salem, M.Z.M. Lemna gibba and Eichhornia crassipes extracts: Clean alternatives for deacidification, antioxidation and fungicidal treatment of historical paper. J. Clean. Prod. 2019, 219, 846–855. [Google Scholar] [CrossRef]
- EL-Hefny, M.; Abo Elgat, W.A.A.; Al-Huqail, A.A.; Ali, H.M. Essential and recovery oils from Matricaria chamomilla flowers as environmentally friendly fungicides against four fungi isolated from cultural heritage objects. Processes 2019, 7, 809. [Google Scholar] [CrossRef]
- Behiry, S.I.; Okla, M.K.; Alamri, S.A.; EL-Hefny, M.; Salem, M.Z.M.; Alaraidh, I.A.; Ali, H.M.; Al-Ghtani, S.M.; Monroy, J.C.; Salem, A.Z.M. Antifungal and antibacterial activities of Musa paradisiaca L. peel extract: HPLC analysis of phenolic and flavonoid contents. Processes 2019, 7, 215. [Google Scholar] [CrossRef]
- Taha, A.S.; Salem, M.Z.M.; Abo Elgat, W.A.A.; Ali, H.M.; Hatamleh, A.A.; Abdel-Salam, E.M. Assessment of the impact of different treatments on technological and antifungal properties of produced Papyrus (Cyperus papyrus L.) sheets. Materials 2019, 12, 620. [Google Scholar] [CrossRef]
- Al-Huqail, A.A.; Behiry, S.I.; Salem, M.Z.M.; Ali, H.M.; Siddiqui, M.H.; Salem, A.Z.M. Antifungal, antibacterial, and antioxidant activities of Acacia saligna (Labill.) Wendl, H.L. flower extract: HPLC analysis of phenolic and flavonoid compounds. Molecules 2019, 24, 700. [Google Scholar] [CrossRef]
- Dhaliwal, H.J.S.; Thind, T.S.; Chander, M. Relative activity of essential oils from plants against Penicillium digitatum causing post-harvest fruit rot of Kinnow mandarin. Plant Dis. Res. 2004, 19, 140–143. [Google Scholar]
- Fiori, A.C.G.; Schwan-Estrada, K.R.F.; Stangarlin, J.R.; Vida, J.B.; Scapim, C.A.; Cruz, M.E.S. Antifungal activity of leaf extracts and essential oils of some medicinal plants against Didymella bryoniae. J. Phytopathol. 2000, 148, 483–487. [Google Scholar] [CrossRef]
- Lee, O.G.; Choi, G.J.; Jang, K.S.; Lim, H.K.; Cho, K.Y.; Kim, J.C. Antifungal activity of five plant essential oils as fumigant against postharvest and soilborne plant pathogenic fungi. Plant Pathol. J. 2007, 23, 97–102. [Google Scholar] [CrossRef]
- Ramezani, H.; Singh, H.P.; Batish, D.R.; Kohli, R.K. Antifungal activity of the volatile oil of Eucalyptus Citriodora. Fitoter. 2002, 73, 261–262. [Google Scholar] [CrossRef]
- Somda, I.; Leth, V.; Sereme, P. Antifungal effect of Cymbopogon citratus, Eucalyptus camaldulensis and Azadirachta indica oil extracts on Sorghum feedborne fungi. Asian J. Plant Sci. 2007, 6, 1182–1189. [Google Scholar]
- USEPA (United States Environmental Protection Agency) 1993. R.E.D. FACTS. Flower and Vegetable Oils. Available online: http://www.epa.gov/oppsrrd1/REDS/factsheets/4097fact.pdf (accessed on 15 September 1993).
- Sebei, K.; Sakouhi, F.; Herchi, W.; Khouja, M.L.; Boukhchina, S. Chemical composition and antibacterial activities of seven Eucalyptus species essential oils leaves. Biol. Res. 2015, 48, 7. [Google Scholar] [CrossRef] [PubMed]
- Salem, M.Z.M.; Elansary, H.O.; Ali, H.M.; El-Settawy, A.A.; Elshikh, M.S.; Abdel-Salam, E.M.; Skalicka-Woźniak, K. Antibacterial, antifungal, and antioxidant activities of essential oils extracted from Cupressus macrocarpa branchlets and Corymbia citriodora leaves grown in Egypt. BMC Complem. Alter. Med. 2018, 18, 23. [Google Scholar] [CrossRef] [PubMed]
- Batish, D.R.; Singh, H.P.; Kohli, R.K.; Kaur, S. Eucalyptus essential oil as a natural pesticide. For. Ecol. Manag. 2008, 256, 2166–2174. [Google Scholar] [CrossRef]
- Habila, N.; Agbaji, A.S.; Ladan, Z.; Bello, I.A.; Haruna, E.; Dakare, M.A.; Atolagbe, T.O. Evaluation of in vitro activity of essential oils against Trypanosoma brucei brucei and Trypanosoma evansi. J. Parasitol. Res. 2010, 2010, 534601. [Google Scholar] [CrossRef]
- Hussein, H.S.; Salem, M.Z.M.; Soliman, A.M. Repellent, attractive, and insecticidal effects of essential oils from Schinus terebinthifolius fruits and Corymbia citriodora leaves on two whitefly species, Bemisia tabaci and Trialeurodes ricini. Sci. Horticul. 2017, 216, 111–119. [Google Scholar] [CrossRef]
- El-Baha, A.M.; El-Sherbiny, A.A.; Salem, M.Z.M.; Sharrawy, N.M.M.; Mohamed, N.H. Toxicity of essential oils extracted from Corymbia citriodora and Eucalyptus camaldulensis leaves against Meloidogyne incognita under laboratory conditions. Pak. J. Nemat. 2017, 35, 93–104. [Google Scholar] [CrossRef]
- Singh, H.P.; Batish, D.R.; Setia, N.; Kohli, R.K. Herbicidal activity of volatile oils from Eucalyptus citriodora against Parthenium hysterophorus. Ann. App. Biol. 2005, 146, 89–94. [Google Scholar] [CrossRef]
- Singh, H.P.; Kaur, S.; Negi, K.; Kumari, S.; Saini, V.; Batish, D.R.; Kohli, R.K. Assessment of in vitro antioxidant activity of essential oil of Eucalyptus citriodora (lemon-scented Eucalypt; Myrtaceae) and its major constituents. LWT Food Sci. Technol. 2012, 48, 237–241. [Google Scholar] [CrossRef]
- Low, D.; Rawal, B.D.; Griffin, W.J. Antibacterial action of the essential oils of some Australian Myrtaceae with special references to the activity of chromatographic fractions of oil of Eucalyptus citriodora. Planta Med. 1974, 26, 184–189. [Google Scholar] [CrossRef] [PubMed]
- AidiWannes, W.; Mhamdi, B.; Sriti, J.; Ben Jemia, M.; Ouchikh, O.; Hamdaoui, G.; Kchouk, M.E.; Marzouk, B. Antioxidant activities of the essential oils and methanol extracts from myrtle (Myrtus communis var. italica L.) leaf, stem and flower. Food Chem. Tox. 2010, 48, 1362–1370. [Google Scholar] [CrossRef] [PubMed]
- Abd EI-Mageed, A.A.; Osman, A.K.; Tawfik, A.Q.; Mohammed, H.A. Chemical composition of the essential oils of four eucalyptus species (Myrtaceae) from Egypt. Res. J. Phytochem. 2011, 5, 115–122. [Google Scholar]
- Batish, D.R.; Singh, H.P.; Setia, N.; Kaur, S.; Kohli, R.K. Chemical composition and inhibitory activity of essential oil from decaying leaves of Eucalyptus citriodora. Z Naturforsch C 2006, 61, 465–471. [Google Scholar] [CrossRef] [PubMed]
- Mittal, A.; Ali, M. Volatile composition of the leaves of Eucalyptus citriodora Hook. Int. J. Res. Ayurveda Pharm. 2011, 2, 509–511. [Google Scholar]
- Delaquis, P.J.; Stanich, K.; Girard, B.; Mazza, G. Antimicrobial activity of individual and mixed fractions of dill, cilantro, coriander and eucalyptus essential oils. Int. J. Food Microbiol. 2002, 74, 101–109. [Google Scholar] [CrossRef]
- Elaissi, A.; Salah, K.H.; Mabrouk, S.; Larbi, K.M.; Chemli, R.; Harzallah-Skhiri, F. Antibacterial activity and chemical composition of 20 Eucalyptus species’ essential oils. Food Chem. 2011, 129, 1427–1434. [Google Scholar] [CrossRef]
- Fahed, L.; Khoury, M.; Stien, D.; Ouaini, N.; Eparvier, V.; El Beyrouthy, M. Essential oils composition and antimicrobial activity of six conifers harvested in Lebanon. Chem. Biodivers. 2017, 14. [Google Scholar] [CrossRef]
- Okla, M.K.; Alamri, S.A.; Salem, M.Z.M.; Ali, H.M.; Behiry, S.I.; Nasser, R.A.; Alaraidh, I.A.; Al-Ghtani, S.M.; Soufan, W. Yield, phytochemical constituents, and antibacterial activity of essential oils from the leaves/twigs, branches, branch wood, and branch bark of Sour Orange (Citrus aurantium L.). Processes 2019, 7, 363. [Google Scholar] [CrossRef]
- NIST/EPA/NIH Mass. Spectral Library (NIST 14) and NIST Mass Spectral Search Program (Version 2.0g) May 2014. Available online: https://www.sisweb.com/software/ms/nist.htm (accessed on 5 March 2019).
- Mansour, M.M.A.; Salem, M.Z.M. Evaluation of wood treated with some natural extracts and Paraloid B-72 against the fungus Trichoderma harzianum: Wood elemental composition, In-vitro and application evidence. Inter. Biodeterior. Biodegrad. 2015, 100, 62–69. [Google Scholar] [CrossRef]
- Mansour, M.M.A.; Abdel-Meged, A.; Nasser, R.A.; Salem, M.Z.M. Comparative evaluation of some woody trees methanolic extracts and Paraloid B-72 against phytopathogenic mold fungi Alternaria tenuissima and Fusarium culmorum. BioRes 2015, 10, 2570–2584. [Google Scholar] [CrossRef]
- Salem, M.Z.M.; Zidan, Y.E.; Mansour, M.M.A.; El Hadidi, N.M.N.; Abo Elgat, W.A.A. Evaluation of usage three natural extracts applied to three commercial wood species against five common molds. Int. Biodeterior. Biodegrad. 2016, 110, 206–226. [Google Scholar] [CrossRef]
- Salem, M.Z.M.; Zidan, Y.E.; Mansour, M.M.A.; El Hadidi, N.M.N.; Abo Elgat, W.A.A. Antifungal activities of two essential oils used in the treatment of three commercial woods deteriorated by five common mold fungi. Int. Biodeterior. Biodegrad. 2016, 106, 88–96. [Google Scholar] [CrossRef]
- SAS. User Guide: Statistics (Release 8.02); SAS Institute: Cary, NC, USA, 2001. [Google Scholar]
- Abd El-Kareem, M.S.M.; Rabbih, M.A.; Elansary, H.O.; Al-Mana, F.A. Mass spectral fragmentation of Pelargonium graveolens essential oil using GC–MS semi-empirical calculations and biological potential. Processes 2020, 8, 128. [Google Scholar] [CrossRef]
- Abd El-Kareem, M.S.M.; El-desawy, M.; Hawash, M.F.; Fahmey, M.A. Structural investigation of sparfloxacin drug using mass spectrometry and MNDO semi-empirical molecular orbital calculations. Inter. J. Advan. Chem. 2018, 6, 74–78. [Google Scholar] [CrossRef]
- Abd El-Kareem, M.S.M.; Rabbih, M.A.; Selim, E.T.M. Semi-empirical and HOMO, LUMO studies of some chlorinated pesticides compounds. Commun. Comput. Chem. 2018, 6, 1–12. [Google Scholar] [CrossRef]
- Abd El-kareem, M.S.M.; Rabbih, M.A.E.-F.; Selim, E.T.M.; Elsherbiny, E.A.E.-M.; El-Khateeb, A.Y. Application of GC/EIMS in combination with semi-empirical calculations for identification and investigation of some volatile components in basil essential oil. Int. J. Anal. Mass Spectrom. Chromatogr. 2016, 4, 14–25. [Google Scholar] [CrossRef]
- Ashmawy, N.A.; Salem, M.Z.M.; EL-Hefny, M.; Abd El-Kareem, M.S.M.; El-Shanhorey, N.A.; Mohamed, A.A.; Salem, A.Z.M. Antibacterial activity of the bioactive molecules identified in three woody plants against some pathogenic bacteria. Microb. Pathog. 2018, 121, 331–340. [Google Scholar] [CrossRef]
- McLafferty, F.W.; Tureček, F. Interpretation of Mass Spectra: University Science Books; University Science Books: Mill Valley, CA, USA, 1993. [Google Scholar]
- Gemperline, E.; Keller, C.; Li, L. Mass Spectrometry in Plant-omics. Anal. Chem. 2016, 88, 3422–3434. [Google Scholar] [CrossRef] [PubMed]
- Jang, M.; Kim, J.; Yoon, K.A.; Lee, S.H.; Park, C.G. Biological activity of Myrtaceae plant essential oils and their major components against Drosophila suzukii (Diptera: Drosophilidae). Pest Manag. Sci. 2017, 73, 404–409. [Google Scholar] [CrossRef] [PubMed]
- Maciel, M.V.; Morais, S.M.; Bevilaqua, C.M.L.; Silva, R.A.; Barros, R.S.; Sousa, R.N.; Sousa, L.C.; Brito, E.S.; Souza-Neto, M.A. Chemical composition of Eucalyptus spp. essential oils and their insecticidal effects on Lutzomyia longipalpis. Vet. Parasitol. 2010, 167, 1–7. [Google Scholar] [CrossRef] [PubMed]
- Bossou, A.D.; Ahoussi, E.; Ruysbergh, E.; Adams, A.; Smagghe, G.; De Kimpe, N.; Avlessi, F.; Sohounhloue, D.C.K.; Mangelinckx, S. Characterization of volatile compounds from three Cymbopogon species and Eucalyptus citriodora from Benin and their insecticidal activities against Tribolium castaneum. Ind. Crops Prod. 2015, 76, 306–317. [Google Scholar] [CrossRef]
- Matasyoh, J.C.; Kiplimo, J.J.; Karubiu, N.M.; Hailstorks, T.P. Chemical composition and antimicrobial activity of essential oil of Tarchonanthus camphorates. Food Chem. 2007, 101, 1183–1187. [Google Scholar] [CrossRef]
- Peana, A.T.; D’Aquila, P.S.; Chessa, M.L.; Moretti, M.D.L.; Serra, G.; Pippia, P. (−)-Linalool produces antinociception in two experimental models of pain. Eur. J. Pharmacol. 2003, 460, 37–41. [Google Scholar] [CrossRef]
- Jeongmok, K.; Marshall, M.R.; Cheng, I.W. Antibacterial activity of some essential oil components against five foodborne pathogens. J. Agric. Food Chem. 1995, 43, 2839–2845. [Google Scholar]
- Magiatis, P.; Skaltsounis, A.L.; Chinou, I.; Haroutounian, S.A. Chemical composition and in vitro antimicrobial activity of the essential oils of three Greek Achillea species. Z. Naturforsch C 2002, 57, 287. [Google Scholar] [CrossRef]
- Javed, S.; Shoaib, A.; Mahmood, Z.; Mushtaq, S.; Iftikhar, S. Analysis of phyto-chemical constituents of Eucalyptus citriodora L. responsible for anti-fungal activity against post-harvest fungi. Nat. Prod. Res. 2012, 26, 1732–1736. [Google Scholar] [CrossRef]
- Shrishti, L.; Vishwanath, S.A.; Vandana, A. Plant essential oils for the management of Rhizoctonia solani causing sheath blight of paddy. Trends Biosci. 2014, 7, 1870–1873. [Google Scholar]
- Ramezani, H.; Singh, H.P.; Batish, D.R.; Kohli, R.K.; Dargan, J.S. Fungicidal effect of volatile oils from Eucalyptus citriodora and its major constituent citronellal. N. Z. Plant Prot. 2002, 327, 327–330. [Google Scholar] [CrossRef]
- Nakahara, K.; Alzoreky, N.S.; Yoshihashi, T.; Nguyen, H.T.T.; Trakoontivakorn, G. Chemical composition and antifungal activity of essential oil from Cymbopogon nardus (Citronella Grass). Jpn. Agric. Res. Q. 2003, 37, 249–252. [Google Scholar] [CrossRef]
- Mohamed, A.A.; Behiry, S.I.; Younes, H.A.; Ashmawy, N.A.; Salem, M.Z.M.; Márquez-Molina, O.; Barbabosa-Pilego, A. Antibacterial activity of three essential oils and some monoterpenes against Ralstonia solanacearum phylotype II isolated from potato. Microb. Pathog. 2019, 135, 103604. [Google Scholar] [CrossRef] [PubMed]
- Oreopoulou, A.; Papavassilopoulou, E.; Bardouki, H.; Vamvakias, M.; Bimpilas, A.; Oreopoulou, V. Antioxidant recovery from hydrodistillation residues of selected Lamiaceae species by alkaline extraction. J. Appl. Res. Med. Arom. Plants 2018, 8, 83–89. [Google Scholar] [CrossRef]
- Rajeswara Rao, B.R.; Kaul, P.N.; Bhattacharya, A.K.; Rajput, D.K.; Syamasundar, K.V.; Ramesh, S. Comparative chemical composition of steam-distilled and water-soluble essential oils of south american marigold (Tagetes minuta L.). J. Essent. Oil Res. 2006, 18, 622–626. [Google Scholar] [CrossRef]
- Sicari, V.; Poiana, M. Essential oil recovery from bergamot juice by supercritical and liquid carbon dioxide. Int. Food Res. J. 2017, 24, 2116–2121. [Google Scholar]
© 2020 by the authors. Licensee MDPI, Basel, Switzerland. This article is an open access article distributed under the terms and conditions of the Creative Commons Attribution (CC BY) license (http://creativecommons.org/licenses/by/4.0/).